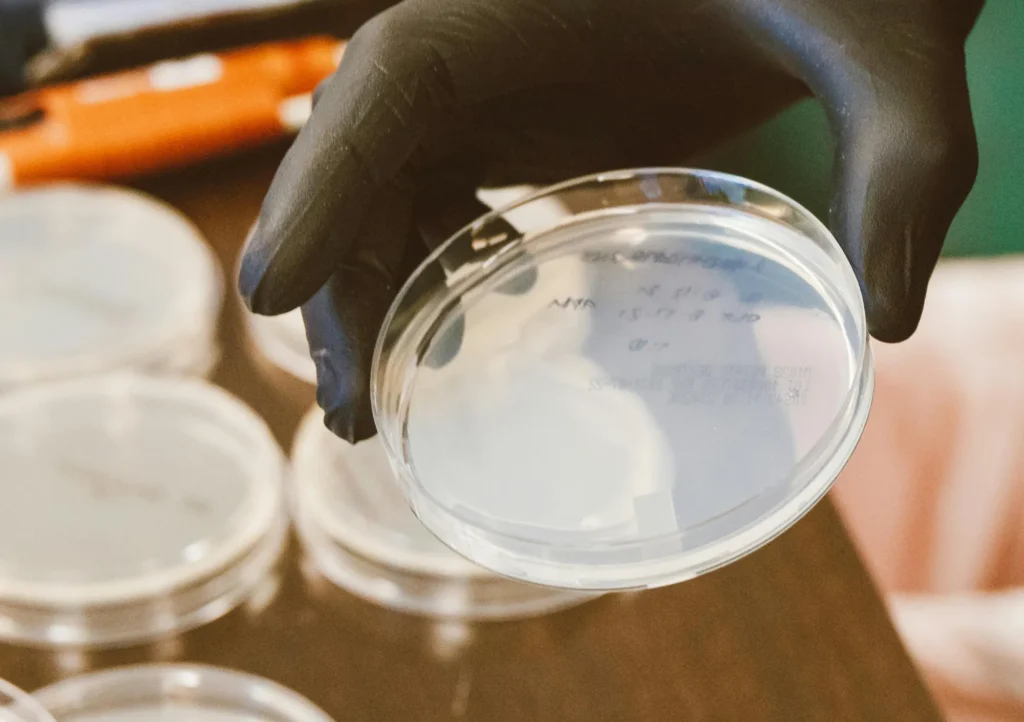

Clinique Vie – Helicobacter Pylori
¿Cómo Detectamos el Helicobacter Pylori?
En Clinique Vie realizamos un diagnóstico completo de la infección por Helicobacter pylori, una de las bacterias gástricas más frecuentes y asociada a problemas como gastritis, acidez, dolor abdominal, digestiones pesadas o molestias persistentes. Detectar esta bacteria de forma precisa es clave para iniciar un tratamiento adecuado y mejorar la salud digestiva.
Nuestro laboratorio ofrece pruebas fiables, no invasivas y de alta precisión para identificar la presencia de Helicobacter pylori y evaluar el estado del sistema digestivo.

Antígeno de Helicobacter pylori en Heces
Esta prueba detecta directamente la presencia de la bacteria en las heces. Es un método eficaz para el diagnóstico inicial y también para comprobar si la infección ha sido eliminada tras el tratamiento.
Test de Aliento de Helicobacter pylori
El test de aliento es una prueba no invasiva que permite identificar la actividad de la bacteria en el estómago. Se utiliza tanto para el diagnóstico como para el control posterior al tratamiento, ofreciendo resultados fiables y rápidos.

EFMI + Patógenos Ampliado
(Microbiota + Helicobacter + Clostridium)
Este estudio avanzado analiza la microbiota intestinal junto con la detección de Helicobacter pylori y otros patógenos como Clostridium. Proporciona una visión completa del equilibrio intestinal y permite valorar el estado digestivo de forma más profunda y personalizada.
Tests para el Helicobacter Pylori en Clinique Vie
Mejora tu salud digestiva con un diagnóstico preciso
Si sufres molestias gástricas, acidez o digestiones pesadas, una evaluación adecuada puede marcar la diferencia. En Clinique Vie te ayudamos a identificar la presencia de Helicobacter pylori para cuidar tu sistema digestivo de forma segura y eficaz.
